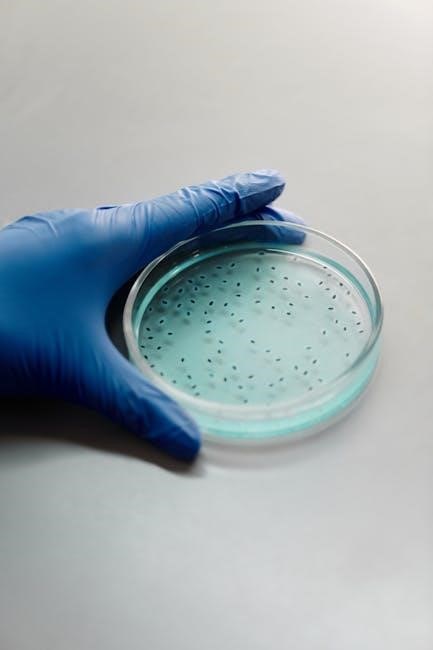

biology: concepts and investigations pdf
Biology: Concepts and Investigations, by Mariëlle Hoefnagels, is a widely used introductory textbook.
It’s available as a PDF, often discussed on platforms like Reddit’s r/FreeTextBook and the Internet Archive.
The textbook emphasizes understanding, not just memorization, and is suitable for one or two-semester courses.
Overview of the Textbook
Biology: Concepts and Investigations, authored by Mariëlle Hoefnagels, presents a comprehensive introduction to biological principles. This textbook distinguishes itself by prioritizing a deeper comprehension of concepts over rote memorization, encouraging students to actively apply their knowledge.
Widely utilized for both one and two-semester introductory biology courses, the book’s content is frequently sought in PDF format, with discussions and links circulating on platforms like Reddit (r/FreeTextBook) and the Internet Archive.
The textbook is known for its accessible narrative and engaging art program, designed to enhance the learning experience.
Mariëlle Hoefnagels is the passionate educator and author behind Biology: Concepts and Investigations. Her guiding principle in crafting this textbook is to move beyond simple fact recall, instead fostering a genuine understanding and application of biological concepts among students.
Hoefnagels’ dedication to effective pedagogy is evident in the textbook’s readable narrative, helpful study tips, and integrated investigative approach. The book’s popularity has led to widespread searches for PDF versions online, discussed on platforms like Reddit and accessible through the Internet Archive.
Target Audience and Course Level
Biology: Concepts and Investigations is designed as an introductory biology textbook, making it ideal for students embarking on their first college-level biology course.
It’s versatile enough to be utilized effectively in either a one-semester or a two-semester course format, catering to diverse academic schedules. The textbook’s accessibility, coupled with its emphasis on conceptual understanding, makes it suitable for a broad range of students seeking a solid foundation in biological principles, often found as a PDF online.
Core Concepts Covered in the Textbook
The textbook comprehensively covers cell structure, molecular biology, evolution, and ecology.
These core areas are presented with a focus on investigations and deeper learning, often accessible as a PDF.
Cell Structure and Function
Biology: Concepts and Investigations dedicates significant attention to the foundational principles of cell structure and function.
Students explore the intricate components of cells – organelles, membranes, and the cytoskeleton – and their roles in maintaining life. The textbook emphasizes how structure dictates function, a core biological concept.
Investigations within the text, and potentially found in associated PDF versions, allow students to actively learn about cellular processes like transport, communication, and energy production. This approach fosters a deeper understanding beyond simple memorization of cellular anatomy.
Molecular Biology and Genetics
Biology: Concepts and Investigations thoroughly covers molecular biology and genetics, starting with DNA structure and replication.
The textbook explains gene expression, protein synthesis, and the mechanisms of inheritance, often utilizing visual aids; PDF versions of the text may include supplementary materials detailing these complex processes.
Students learn about mutations, genetic variation, and the principles of Mendelian genetics. The investigative approach encourages applying these concepts to solve problems and analyze data, enhancing comprehension beyond rote learning.
Evolution and Natural Selection
Biology: Concepts and Investigations dedicates significant coverage to evolution and natural selection, foundational concepts in biology.
The textbook explores evidence for evolution, including fossil records, comparative anatomy, and molecular data; PDF versions available online often retain the detailed illustrations supporting these explanations.
Students investigate mechanisms of evolutionary change, such as genetic drift and gene flow. Hoefnagels’ approach emphasizes understanding how natural selection drives adaptation and the diversity of life, fostering critical thinking.
Ecology and Ecosystems
Biology: Concepts and Investigations thoroughly examines ecology and ecosystems, detailing interactions between organisms and their environment.
The textbook explores topics like population dynamics, community structure, and energy flow through ecosystems. PDF copies readily found online maintain the textbook’s visual aids illustrating these complex relationships.
Hoefnagels emphasizes the importance of biodiversity and conservation, prompting students to analyze human impacts on ecological systems. The investigative approach encourages applying ecological principles to real-world scenarios.

Key Features and Pedagogical Approach
Biology: Concepts and Investigations utilizes a readable narrative, a strong art program, and study tips.
PDF versions retain these features, supporting deeper learning through an investigative, application-focused approach.
Emphasis on Deeper Learning
Biology: Concepts and Investigations distinguishes itself by prioritizing comprehension and application over rote memorization.
Author Mariëlle Hoefnagels guides students to truly understand biological principles, fostering critical thinking skills. Even in PDF format, the textbook’s design encourages active learning.
This approach moves beyond simply recalling facts, prompting students to analyze data, interpret results, and connect concepts. The textbook’s structure, even in a downloadable PDF, supports this goal, making it a valuable resource for meaningful engagement with biology.
Readable Narrative and Art Program
Biology: Concepts and Investigations is traditionally recognized for its exceptionally clear and accessible writing style.
Even when accessed as a PDF, the textbook’s narrative remains engaging and easy to follow. Complementing the text is a robust art program, featuring high-quality illustrations and diagrams.
These visuals enhance understanding and reinforce key concepts, making complex topics more approachable. The combination of a readable narrative and strong visual aids contributes significantly to the textbook’s effectiveness, even in digital PDF form.
Study Tips and Resources
Biology: Concepts and Investigations incorporates helpful study tips directly within the text, aiding student comprehension and retention.
Even when utilizing a PDF version, these embedded resources remain accessible. Supplemental online materials, though not explicitly detailed in the provided snippets, likely accompany the textbook.
Students can also benefit from external resources like NCERT solutions for supplementary practice. Accessing the textbook as a PDF doesn’t diminish the availability of these learning aids, enhancing the overall study experience.
Investigative Approach to Biology
Biology: Concepts and Investigations distinguishes itself through its “Invest” feature, encouraging active learning and experimentation.
Even with a PDF version, students can still engage with the core principles of scientific inquiry presented in the textbook.
The text emphasizes data analysis and interpretation, skills honed through included laboratory exercises. This approach moves beyond rote memorization, fostering a deeper understanding of biological concepts, regardless of the access format—physical or PDF.

Accessing the Textbook
Biology: Concepts and Investigations (ISBN: 9781265340186) is available as an eBook and PDF, found via online resources and supplements.
Unofficial PDF downloads exist on platforms like the Internet Archive.
ISBN: 9781265340186
Biology: Concepts and Investigations, identified by ISBN 9781265340186, facilitates easy textbook identification and procurement. This ISBN is crucial when searching for the textbook, whether purchasing a physical copy or seeking digital versions like a PDF.
Online platforms frequently utilize this ISBN for accurate listings. Discussions on Reddit (r/FreeTextBook) and resources like the Internet Archive often reference this number when sharing or locating the textbook’s PDF format.
Confirming the ISBN ensures you’re accessing the correct edition of Hoefnagels’ work.
Availability of eBook Versions
Biology: Concepts and Investigations is available in eBook formats, offering students convenient access to the material. While official eBook purchases are available through McGraw Hill and other retailers, PDF versions are frequently sought online.
Platforms like the Internet Archive host digitized copies, and discussions on Reddit’s r/FreeTextBook often share links to these PDFs. However, caution is advised when downloading from unofficial sources due to potential copyright concerns and file safety.
Legitimate eBook access provides a reliable learning experience.
Online Resources and Supplements
Alongside the Biology: Concepts and Investigations textbook, numerous online resources enhance the learning experience. While searching for a PDF version, students can also find supplementary materials from McGraw Hill’s website.
These resources often include practice quizzes, interactive exercises, and additional content to reinforce key concepts. Furthermore, communities like Reddit’s r/FreeTextBook may share links to helpful study guides and solutions manuals.
NCERT solutions can also supplement understanding.

Finding PDF Versions Online
Biology: Concepts and Investigations PDFs are frequently sought on platforms like Reddit (r/FreeTextBook) and the Internet Archive, though caution is advised.
Unofficial downloads carry potential risks.
Reddit Discussions (r/FreeTextBook)
Reddit’s r/FreeTextBook is a common hub for students seeking affordable or free access to textbooks, including Biology: Concepts and Investigations. Discussions frequently arise regarding PDF availability, with users sharing potential download links.
A link shared in January 2023, hosted on Cloudflare IPFS, pointed to a version of the 5th edition by Hoefnagels. However, users should exercise caution when utilizing links from such forums, verifying the source and scanning for potential malware before downloading any files. The subreddit serves as a dynamic resource, but requires diligent verification.
Internet Archive Availability
The Internet Archive offers access to Biology: Concepts and Investigations, providing options for borrowing, streaming, and downloading. Advanced embedding details and help resources are available for enhanced user experience.
The archive’s record identifies the work with specific URNS for LCP (lifecycle PDF) and OCLC records, indicating its cataloged status. Users can explore the textbook online or download it, potentially in various formats. This platform provides a legitimate avenue for accessing the textbook, though availability may vary.
Potential Risks of Unofficial Downloads
Downloading Biology: Concepts and Investigations from unofficial sources carries significant risks; These include the potential for malware infections, viruses, and compromised data security; Illegally obtained PDFs may contain harmful software disguised as educational material.
Furthermore, accessing copyrighted content without authorization is a violation of legal and ethical standards. Supporting legitimate sources ensures the author receives due compensation and encourages continued quality content creation. Prioritize official channels for a safe and ethical learning experience.
NCERT Biology Correlation
NCERT Class 11 Biology materials can supplement Biology: Concepts and Investigations, aiding comprehension and providing additional practice questions for students.
Utilizing both resources enhances learning and exam preparation.
Relevance to Class 11 Biology Curriculum
Biology: Concepts and Investigations can effectively complement the NCERT Class 11 Biology syllabus, offering a broader perspective on core concepts. While NCERT provides a foundational understanding tailored to the Indian curriculum, Hoefnagels’ textbook delves deeper into investigative approaches and expands upon topics like cell structure, genetics, and ecological principles.
Students utilizing both resources benefit from a comprehensive grasp of biological principles, strengthening their preparation for competitive exams and fostering a more nuanced understanding of life sciences. The textbook’s emphasis on application aligns well with the evolving educational landscape.
Using NCERT Solutions as a Supplement
NCERT Solutions for Class 11 Biology serve as an excellent supplementary resource when studying with Biology: Concepts and Investigations. They provide focused practice on concepts directly aligned with the Indian school curriculum, reinforcing understanding.
Students can utilize NCERT solutions to solidify their grasp of fundamental principles, while Hoefnagels’ textbook offers broader context and investigative exercises. This combined approach fosters a robust learning experience, enhancing exam preparation and promoting deeper conceptual clarity.

Google Books Preview
Biology: Concepts and Investigations offers a preview on Google Books, allowing exploration of sample chapters.
This provides insight into the textbook’s scope and approach before purchasing or downloading a PDF version.
Exploring Sample Chapters
Biology: Concepts and Investigations, accessible via Google Books, allows prospective students to delve into select chapters before committing to a purchase.
This preview feature is invaluable for assessing the textbook’s suitability for individual learning styles and course requirements. Users can examine the narrative style, art program, and investigative approach championed by author Mariëlle Hoefnagels.
Furthermore, the preview offers a glimpse into the depth of coverage for core concepts, potentially aiding in the decision to acquire a physical copy or explore available PDF resources online.
Understanding the Textbook’s Scope
Biology: Concepts and Investigations is designed for introductory biology courses, spanning either one or two semesters.
The textbook’s scope extends beyond rote memorization, prioritizing a deeper comprehension of fundamental biological principles. It covers core areas like cell structure, molecular biology, evolution, and ecology.
Students can expect an investigative approach, supported by a readable narrative and a robust art program, making complex topics more accessible, even when exploring PDF versions found online.

The Shift in Biology Education
Biology: Concepts and Investigations reflects a move away from memorization towards application and understanding core principles, even in PDF format.
This approach fosters critical thinking skills.
Moving Beyond Memorization
Biology: Concepts and Investigations, accessible as a PDF, actively encourages students to move beyond rote memorization of biological facts.
Author Mariëlle Hoefnagels prioritizes a deeper comprehension and practical application of course content.
This pedagogical shift, evident in the textbook’s design and investigative approach, aims to cultivate critical thinking and problem-solving abilities.
The focus is on understanding the ‘why’ behind biological processes, rather than simply recalling ‘what’ they are, even when utilizing freely available PDF versions.
Focus on Application and Understanding
Biology: Concepts and Investigations, often found as a PDF online, centers its approach on applying biological principles to real-world scenarios.
Mariëlle Hoefnagels’ textbook doesn’t merely present information; it challenges students to utilize their knowledge through investigative exercises.
This emphasis on understanding fosters a more robust and lasting grasp of complex biological concepts, even when accessed via unofficial PDF downloads.
The textbook’s design actively promotes critical thinking and analytical skills, moving beyond simple recall of facts.

Specific Investigations and Experiments
Biology: Concepts and Investigations includes laboratory exercises, focusing on data analysis and interpretation.
These investigations are a core component, even when utilizing PDF versions of the textbook.
Laboratory Exercises Included
Biology: Concepts and Investigations integrates practical laboratory work directly into the learning experience. Even when accessing the textbook as a PDF, the importance of these hands-on components remains central to understanding core biological principles.
The book features a range of exercises designed to reinforce concepts through direct application. These aren’t merely procedural; they emphasize critical thinking and the development of scientific skills. Students actively engage with the material, fostering a deeper, more lasting comprehension than rote memorization allows.
These labs are designed to complement the narrative and art program, enhancing the overall pedagogical approach.
Data Analysis and Interpretation
Biology: Concepts and Investigations doesn’t simply present experimental results; it actively guides students through the process of data analysis and interpretation. This is a crucial skill, even when utilizing a PDF version of the textbook for study.
The text emphasizes understanding how conclusions are drawn from evidence, not just accepting them as facts. Students learn to critically evaluate data sets, identify trends, and formulate logical explanations.
This analytical approach extends beyond the laboratory exercises, fostering a broader scientific mindset applicable to various fields of study.
Textbook Updates and Editions
Biology: Concepts and Investigations has seen multiple editions, with the 5th edition (2020) being a current version.
PDF versions may represent older editions, so checking the publication date is vital.
Changes in the 5th Edition
Biology: Concepts and Investigations’ 5th edition, published in 2020, builds upon previous versions with updated content and refined pedagogical features. While specific detailed changes aren’t explicitly outlined in readily available summaries, the core philosophy of emphasizing conceptual understanding over rote memorization remains central.
PDF versions circulating online may not reflect these updates, potentially containing information from earlier editions. Users seeking the most current information should verify the edition when accessing a Biology: Concepts and Investigations PDF. The art program and narrative style, traditionally strengths of the textbook, likely received further enhancements.
Comparison of Editions
Older PDF versions of Biology: Concepts and Investigations, predating the 5th edition (2020), may lack the most current research and updated examples. While foundational concepts remain consistent across editions, the 5th edition likely incorporates advancements in biological understanding and pedagogical approaches.
Accessing a PDF from sources like the Internet Archive requires verifying the publication date. Students should confirm their course requires a specific edition to avoid discrepancies. The art program and study resources have been refined over time, making newer editions more effective.

Criticisms and Limitations
Some users seek free PDF versions, potentially encountering outdated or low-quality scans. Alternative textbooks may offer different approaches or specialized content.
Ethical sourcing of materials is crucial when considering unofficial downloads.
Potential Areas for Improvement
While Biology: Concepts and Investigations is well-regarded, some areas could benefit from enhancement. The availability of free PDF versions, while convenient, often leads to access of potentially outdated editions or compromised quality scans.
Expanding the digital resources, particularly interactive simulations and updated data sets, would further support deeper learning. Addressing the need for more comprehensive coverage of rapidly evolving fields like genomics and personalized medicine could also strengthen the textbook’s relevance.
Furthermore, incorporating more diverse case studies and real-world applications could enhance student engagement.
Alternative Biology Textbooks
For students seeking alternatives to Biology: Concepts and Investigations, several excellent options exist. Campbell Biology remains a gold standard, offering comprehensive coverage, though it can be more dense. Raven Biology of Plants is ideal for botany-focused courses.
Pearson’s Biology by Solomon, Martin, and Martin provides a strong foundation, while OpenStax Biology offers a free, openly licensed alternative. Considering learning style and course emphasis is crucial when selecting a textbook.
Exploring sample chapters and comparing pedagogical approaches can aid in informed decision-making.

Impact on Student Learning
Biology: Concepts and Investigations fosters improved conceptual understanding and enhances critical thinking skills through its investigative approach and emphasis on application.
Students move beyond rote memorization.
Improved Conceptual Understanding
Biology: Concepts and Investigations actively promotes a deeper grasp of biological principles, shifting the focus away from simple memorization of facts.
The textbook’s design, coupled with its investigative approach, encourages students to truly understand the ‘why’ behind biological processes, rather than just recalling ‘what’ happens.
This is achieved through a readable narrative, a strong art program, and features designed to help students apply course content, leading to more robust and lasting knowledge.
Enhanced Critical Thinking Skills
Biology: Concepts and Investigations isn’t just about learning facts; it’s about learning how to think like a biologist.
The textbook’s investigative approach, including laboratory exercises and data analysis, actively cultivates critical thinking skills.
Students are challenged to interpret information, draw conclusions, and apply their knowledge to new situations, mirroring the real-world problem-solving skills essential in scientific fields.
This focus moves beyond rote learning, fostering analytical abilities.
Legal Considerations
Downloading unofficial PDF versions raises copyright concerns.
Ethical sourcing and respecting fair use are crucial when accessing educational materials like Biology: Concepts and Investigations.
Copyright and Fair Use
Accessing Biology: Concepts and Investigations as a PDF requires careful consideration of copyright law. Unauthorized distribution of copyrighted material, like this textbook, is illegal.
“Fair use” allows limited use of copyrighted material for purposes like education, criticism, or research, but downloading and sharing entire textbooks generally exceeds these boundaries.
Students should prioritize legally obtained copies through purchase or library access to avoid potential legal ramifications and support the author’s intellectual property rights.
Ethical Sourcing of Materials
Obtaining Biology: Concepts and Investigations ethically supports the author, Mariëlle Hoefnagels, and the publishing industry. Utilizing legally purchased copies or accessing the textbook through institutional subscriptions ensures fair compensation for their work.
While free PDF versions circulate online, downloading from unofficial sources can contribute to copyright infringement and undermine educational resources.
Prioritizing ethical sourcing demonstrates respect for intellectual property and fosters a sustainable ecosystem for educational materials.